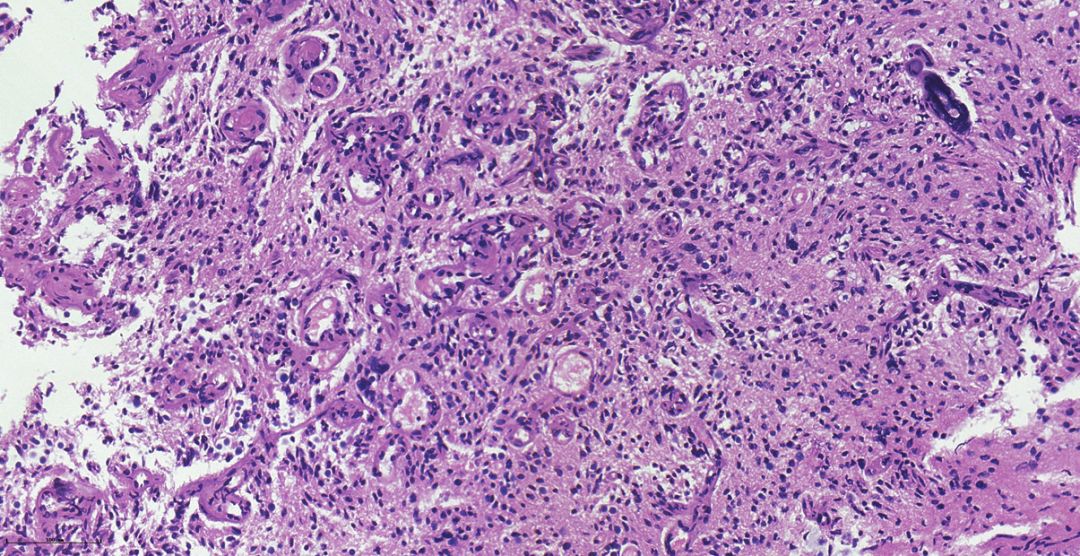
1,术中冰冻病理报的是高级别胶质瘤.

胶质瘤病理

用胶质瘤开启神经系统肿瘤之门下
图片尺寸1080x735
脑干胶质瘤
图片尺寸1280x1024
胶质母细胞瘤的初始治疗_胶质瘤_介绍_治疗方式_日常注意事项 - 好
图片尺寸2202x1410
胶质瘤手术治疗案例分享_胶质瘤_胶质瘤治疗方式 - 好大夫在线
图片尺寸3968x2976
病理学术语:胶质瘤
图片尺寸1055x913
胶质瘤的分类和病理诊断
图片尺寸1080x1080
伴h3g34r突变的弥漫性半球胶质瘤一例神经病理系列二浙二神外周刊第
图片尺寸1080x1070
警惕"发现即晚期"!11岁男孩头痛,复视竟查出恶性胶质瘤
图片尺寸760x589
1,术中冰冻病理报的是高级别胶质瘤.
图片尺寸1080x556
右额上皮样胶质母细胞瘤一例(神经病理系列九)---浙二神外周刊(第347
图片尺寸620x549
胶质瘤
图片尺寸650x500
上皮样胶质母细胞瘤一例(2018华东胶质瘤mdt病例二)--浙二神外周刊(第
图片尺寸596x566
胶质瘤手术治疗案例分享_胶质瘤_胶质瘤治疗方式 - 好大夫在线
图片尺寸3968x2976
idh1突变型胶质母细胞瘤临床病理分析
图片尺寸839x654
用胶质瘤开启神经系统肿瘤之门下
图片尺寸1080x713
腺样型胶质母细胞瘤1例
图片尺寸470x527
病理结果:腹膜胶质瘤病
图片尺寸475x337
从病理学诊断角度谈,胶质瘤病理诊断如何从组织学表型向分子表型演化
图片尺寸960x720
胶质瘤
图片尺寸653x500
37岁男性,右颞叶"胶质瘤"术后半年,现复发.4×10b
图片尺寸1024x768